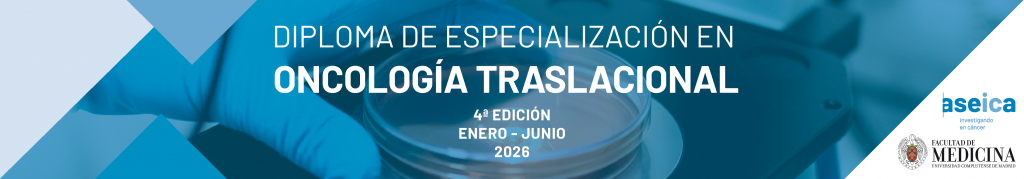

En GUARD Consortium tenemos como principal objetivo la investigación clínica y traslacional en tumores genitourinarios. Estamos comprometidos en fomentar la investigación, el intercambio de conocimientos y la promoción de soluciones innovadoras en este campo. Nuestro propósito es promover el desarrollo de proyectos de investigación orientados a optimizar los resultados en salud con un enfoque multidisciplinar.
En nuestro compromiso con la investigación y nuestro continuo interés en crecer, actualmente lideramos más de 30 proyectos entre propios y en colaboración.
Queremos ser el partner de referencia en proyectos científicos e incentivar a que los investigadores contribuyan con sus propuestas.
Proyectos GUARD Consortium
Actualmente GUARD Consortium gestiona los siguientes proyectos de investigación:
Próstata
Renal
Vejiga temprana
Vejiga avanzada
Becas GUARD Consortium
En GUARD Consortium estamos comprometidos con la investigación y queremos promover la financiación de estudios de investigación traslacional y
clínica que ayuden en el avance del conocimiento y desarrollo en tumores genitourinarios.
Involucrados en la formación y apoyo a los profesionales más jóvenes, lanzamos nuestro Programa de BECAS con el objetivo de que el
aprendizaje obtenido se comparta y difunda, beneficiando a más profesionales y más instituciones nacionales y, en última instancia, a más
personas y pacientes de nuestra sociedad.

GUARD CONSORTIUM tienen el placer de convocar la BECA GUARD Consortium en carcinoma de vejiga músculo-invasivo localizado con el objetivo de facilitar a los investigadores en cáncer genitourinario el acceso a recursos para la investigación y promover y desarrollar proyectos de investigación clínica y/o traslacional independiente en el ámbito de los tumores genitourinarios.
Ganadora de la Beca GUARD Consortium en carcinoma de vejiga músculo-invasivo localizado
1 premio de 25.000€
Mª JOSÉ JUAN FITA,
Instituto Valenciano de Oncología, Valencia
Proyecto
Evaluación de la respuesta al tratamiento neoadyuvante en MIBC. Acrónimo Propuesto: REVICTO (Respuesta Evaluada po VI-RADS y ctDNA)
Plazos de la convocatoria
- Lanzamiento Beca: 31 de julio de 2025
- Cierre recepción de candidaturas: 31 de octubre de 2025 a las 23h
- Fallo Beca: finales de noviembre de 2025
- El 11 de diciembre de 2025, se hará público el fallo y se entregará la Beca en la Jornada de Acceso a Fármacos, Girona
Con la colaboración de:

Diploma de Especialización en Oncología Traslacional ASEICA – UCM 2026
GUARD Consortium ofrece 2 becas a sus Faculty Members para cursar el Diploma de Especialización en Oncología Traslacional, organizado por ASEICA y la Universidad Complutense de Madrid (UCM) en 2026.
Para que puedas optar a las becas, necesitaremos que nos envíes la siguiente documentación:
- CVA
- Vídeo presentación (duración máxima 1 minuto): Preséntate y explícanos porqué te gustaría cursar esta formación.
- Datos personales (nombre + apellido, Institución profesional…)
- Enviar a: info@guardconsortium.org
A tener en cuenta:
- El importe de la beca no incluye los 40€ del coste de la pre-matrícula.
- La concesión de la beca está condicionada a una evaluación y a la admisión del beneficiario en el proceso de selección de la UCM.
- El beneficiario deberá ser miembro de ASEICA.
ganadores de la Beca del Diploma de especilaización en oncología traslacional
LAURA GABIRONDO AMENABAR,
Hospital Universitario Donostia, San Sebastián
IKER MUÑAGORRI QUILES,
Hospital Universitario Donostia, San Sebastián
GANADORES BECAS GUARD Consortium en Medicina de precisión en cáncer de Vejiga metastásico 2025
[ BECA JOVEN ]
2 premios de 20.000€ cada una
LUCIA TRILLA FUERTES,
Hospital Universitario La Paz, Madrid
Proyecto
Identificación de biomarcadores séricos predictivos de respuesta y toxicidad al tratamiento sistémico con Enfortumab-Vedotin + Pembrolizumab en carcinoma urotelial metastásico
PABLO JARA MARTÍN,
Hospital General Universitario Gregorio Marañón, Madrid
Proyecto
Mecanismos de resistencia a la inmunoterapia en pacientes con tumores de vejiga o del tracto urinario metastásico (TVTUm) e histología no urotelial pura o mixta (PROYECTO CHESSY)
[ BECA SENIOR ]
Premio de 37.000€
ALBERT FONT POUS, Institut Català d’Oncologia (ICO), Badalona
Proyecto
PROBLADDER-II: análisis prospectivo de biomarcadores predictivos y pronósticos en tejido, plaquetas educadas por el tumor y ADN tumoral circulante en pacientes con cáncer de vejiga avanzad

Programa de mentorización
El grupo de trabajo Mentorship Research Group, lanza un programa de mentorización, que tiene como objetivo formar y acompañar a nuevos
líderes de investigación GU.
Queremos Potenciar la carrera científica de los miembros más jóvenes de la Sociedad, asesorándoles en su labor diaria a través del programa de
mentoría.
Detalles del programa:
- Duración de un año. Fecha prevista lanzamiento enero 2025.
- 9 grupos de mentorización formados por 1 mentorizado y 2 o más mentores de diferentes especialidades para que el enfoque sea multidisciplinar.
- Los participantes tendrán la oportunidad de desarrollar un proyecto de investigación con la supervisión y guía de sus mentores.
- A la mitad del programa, en junio 2025, se realizará una exposición preliminar de los proyectos.
- Los participantes pueden proporcionar su propia idea de proyecto, que será valorado por la coordinación del grupo (1 hoja máximo) o por el contrario
los mentores les sugerirán un proyecto.
Si eres un jóven investigador te invitamos a participar en este programa. Tienes de plazo hasta el 15 de diciembre.
Proyectos GUARD Consortium
Actualmente GUARD Consortium gestiona los siguientes proyectos de investigación:
Próstata
Renal
Vejiga temprana
Vejiga avanzada
Proyectos GUARD Consortium
Actualmente GUARD Consortium gestiona los siguientes proyectos de investigación:
| Registro SC | Nombre de proyecto | GT / Patología | Tipo de actividad | Tipo de proyecto | Coordinador | Estado |
|---|---|---|---|---|---|---|
| 2023-02 | Prediction model of Bacille Calmette Guerin (BCG) resistance in non muscle infiltrating bladder carcinomas – Redbladder Study | Vejiga temprana | INVESTIGACIÓN | PROPIO | Dr. Javier Puente, Núria Malats | ABIERTO |
| 2023-06 | Estudio Stampede2 | Próstata | INVESTIGACIÓN | PROPIO | Dr. Castellano | ABIERTO |
| 2023-11 | Guías clínicas Cáncer de próstata hormonosensible metastásico (CPHSM) | Próstata | INVESTIGACIÓN | PROPIO | Dr. Pablo Maroto | ABIERTO |
| 2024-29 | Documento de consenso del tratamiento a progresión de pembrolizumab en adyuvancia | Renal | INVESTIGACIÓN | PROPIO | Dra. Teresa Alonso, Dr. Pablo Maroto | ABIERTO |
| 2024-35 | Enfants | Vejiga avanzada | INVESTIGACIÓN | PROPIO | Dr. Daniel Castellano y Dr. Jorge Esteban Villarubia | ABIERTO |
| 2024-38 | Registro prospectivo nacional de subtipos histológicos | Vejiga temprana | INVESTIGACIÓN | PROPIO | Dr. Guerrero-Ramos, Dr.Rodríguez Faba | SIN INICIAR |
| 2024-39 | ctDNA (NATERA kit habitual o personalised per pt- no existed quelcom similar a k-ras). Include alters marcadors cirulants (perfil immune) | Vejiga temprana | INVESTIGACIÓN | PROPIO | Dra. Nuria Sala, Dra. Carme Mir | SIN INICIAR |
| 2024-40 | Documento de consenso sobre adyuvancia- tenant | Vejiga temprana | INVESTIGACIÓN | PROPIO | Dra. Nuria Sala, Dra. Carme Mir | ABIERTO |
| 2024-41 | Estudio del papel de la RMN | Vejiga temprana | INVESTIGACIÓN | PROPIO | Dr. Jerónimo Barrera y Dr. Javier Puente | SIN INICIAR |
| 2024-45 | [CHESSY-1] – Patterns of response in urothelial variants and non-urothelial bladder carcinomas treated with Immunotherapy in Europe . | Vejiga avanzada | INVESTIGACIÓN | COLABORACIÓN | Dr. Pablo Jara | ABIERTO |
| 2024-48 | Documento de consenso sobre utilización de Radio-223 en cáncer de próstata | Próstata | INVESTIGACIÓN | PROPIO | Dr. Álvaro Pinto | ABIERTO |
| 2024-49 | Estudio THUNDER | Próstata | INVESTIGACIÓN |
COLABORACIÓN | Dr. Castellano | ABIERTO |
| 2024-54 | Documento de consenso cancer renal SBRT | Renal | INVESTIGACIÓN | PROPIO | Dr. Abraham Ocanto | ABIERTO |
| 2024-55 | Estudio prospectivo en el cáncer renal con trombo en cava | Renal | INVESTIGACIÓN | PROPIO | Dr. Rodríguez Faba y Dr. Maroto | ABIERTO |
| 2024-57 | Proyecto ART | Renal | INVESTIGACIÓN | COLABORACIÓN | Dr. Jesús Garcia Donas y Dra. Cristina Rodríguez | ABIERTO |
| 2024-58 | Documento de consenso sobre el papel de las combinaciones de TKi + IO en cáncer renal avanzado | Renal | INVESTIGACIÓN | PROPIO | Dr. Javier Puente, Dra. Nuria Sala | SIN INICIAR |
| 2024-59 | Proyecto Arenal | Renal | INVESTIGACIÓN | PROPIO | Dra. Teresa Alonso y Dra. Natalia Vidal | SIN INICIAR |
| 2024-61 | Proyecto PSMA test | Próstata | INVESTIGACIÓN | PROPIO | Dr. Antonio Rodríguez | SIN INICIAR |
| 2024-63 | Generación de organoides derivados de pacientes con cáncer de próstata para la identificación de biomarcadores y nuevos mecanismos de acción de los inhibidores de PARP | Próstata | INVESTIGACIÓN | COLABORACIÓN | Dr. Juan Fco. Rodríguez Moreno | SIN INICIAR |
| 2024-64 | REINFORCE study design Phase 2 randomized trial | Próstata | INVESTIGACIÓN | COLABORACIÓN | Dr. Enrique Gonzalez Billalabeitia | SIN INICIAR |
| 2024-65 | Proyecto Desintensificación de tratamiento en CPHSm de bajo volumen con buena respuesta inicial | Próstata | INVESTIGACIÓN | PROPIO | Dr. David Lorente | SIN INICIAR |
| 2024-66 | Panel de IHC “predictor” de ausencia de alteraciones en FGFR | Vejiga avanzada | INVESTIGACIÓN | PROPIO | Dr. Álvaro Pinto | SIN INICIAR |
| 2024-67 | Estudio descriptivo de la eficacia de trastuzumab deruxtecan en cáncer de vejiga metastásico con expresión de HER2 | Vejiga avanzada | INVESTIGACIÓN | PROPIO | Dr. Alberto Carretero y Dr.Guillermo de Velasco | SIN INICIAR |
| 2024-71 | European Registry of Next Generation Imaging in Advanced Prostate Cancer | Próstata | INVESTIGACIÓN | COLABORACIÓN | Dr. Francesco Sanguedolce | ABIERTO |
| 2024-68 | Estudio AxIn | Renal | INVESTIGACIÓN | COLABORACIÓN | Dr. Durán, Dr. Puente y Dr. Guillermo de Velasco | ABIERTO |
| 2024-69 | Immunotherapy rechallenge in urothelial cancer | Vejiga avanzada | INVESTIGACIÓN | PROPIO | Dra. Elena Sevillano | SIN INICIAR |
Estudio STAMPEDE2
- Proyecto propio
- Coordinador: Dr. Daniel Castellano
Estudio STAMPEDE2
- Proyecto propio
- Coordinador: Dr. Daniel Castellano
Guías clínicas Cáncer de próstata hormonosensible metastásico (CPHSM)
- Proyecto propio
- Coordinador: Dr. Pablo Maroto
Documento de consenso sobre utilización de Radio-223 en cáncer de próstata
- Proyecto propio
- Coordinador: Dr. Álvaro Pinto
Estudio STAMPEDE2
- Proyecto propio
- Coordinador: Dr. Daniel Castellano
Guías clínicas Cáncer de próstata hormonosensible metastásico (CPHSM)
- Proyecto propio
- Coordinador: Dr. Pablo Maroto
Documento de consenso sobre utilización de Radio-223 en cáncer de próstata
- Proyecto propio
- Coordinador: Dr. Álvaro Pinto
Artículos publicados
[Renal] - Técnicas ablativas para tumores renales en pacientes inoperables: Un paso adelante en la SBRT
[Próstata] - Triplet systemic therapy for hormone-sensitive prostate cancer: a critical review with a multidisciplinary approach
[Cáncer Próstata] - Recomendaciones de tratamiento en el cáncer de próstata hormonosensible metastásico.
[Cáncer Próstata] - El papel del radio-223 en el cambiante panorama del tratamiento del cáncer de próstata metastásico resistente a la castración: una revisión narrativa.
[Cáncer Renal] - Consenso de expertos sobre los patrones de progresión del cáncer de riñón después de la inmunoterapia adyuvante y las estrategias de tratamiento posteriores
Envía tu proyecto
Envía tu proyecto a GUARD Consortium
Sé parte del cambio en la lucha contra los tumores genitourinarios.
Si quieres enviar un proyecto científico a GUARD, te invitamos a cumplimentar el formulario del enlace.

